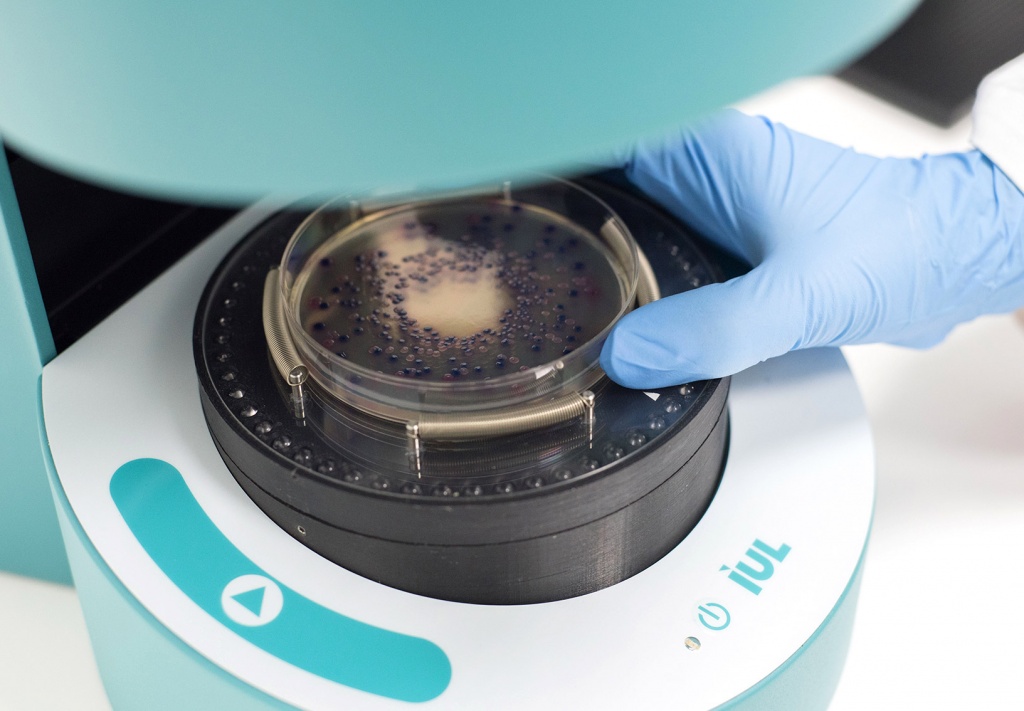
IGZ Instruments, Automatic colony counter SphereFlash

Automatic colony counter SphereFlash
Count colonies without disturbing reflections. CFR21 Part 11 compliant.
Main benefits
Highest accuracy
The patented spherical chamber eliminates reflections, both on the colonies and on the Petri dishes, allowing uniform illumination. Better, more reliable and more consistent results thanks to improved image capture.
Disk evaluation
Simple and automatic generation of user-defined statistical reports, including the use of any number of panels.
Patent solution
A single device for all plate types. The adapters and centering devices are designed for different diameters so that the plates can be exchanged at any time.
Broad colony count spectrum
Simple & intuitive, powerful software. Even the LITE version
is able to detect many different colonies with minimal or no user parameterization.
Audit trail & user management
Both SphereFlash® software, Colonies PRO & Halos PRO, comply with the requirements of 21 CFR Part 11 of the US FDA. Safety-relevant data records, in chronological order, provide documentary evidence of the individual work steps of a specific work process.
High resolution
With the Colonies-LITE or Colonies-PRO software, the SphereFlash® is able to detect 0.3 mm/0.046 mm colonies.
Video colony counter SphereFlash
Automatically count colonies in one second
IGZ Instruments AG - Your inquiry forAutomatic colony counter SphereFlash